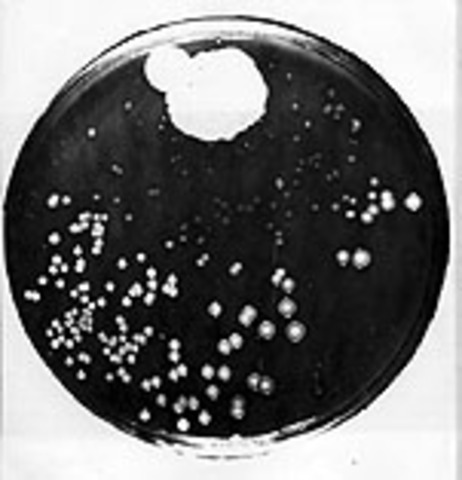
Alexandra Fleming Found Bateria Growing

-
Sir Alexander Fleming was bon on the 6th of august 1881 in Lochfield, Ayrshire, Scotland.
-
-
in the 1920's Alexandra Fleming was searching for an effecrtive antispetic in his lab. This is when he discoveres Lysozome which is an enzyme that is found naturally in sweat and tears.
-
In 1928 Alexandra Fleming discovered Penicillin a antibiotic.
-
As Alexandra Fleming just discovered Lysozome, his lab was in a mess. One day Alexandra Fleming was cleaning up his lab when he came acrosss a pile of petri dishes which contained bacteria that he forgotten he had been growing. Before placing the petri dishes into cleaning fluid he realosed that mould was growing on it. In itself this was nothing unusual but, on this particular esample, all around the mould the bacterua he had been growing was dead.
-
In 1930, Cecil George Paine attempted to use penicillin to treat sycosis barbae and eruptions in beard follicles, but was unsuccessful.
-
Alexandra Fleming cured a patient using Penicillin. Tis was the first time he cured somebody with Penicillin.
-
John Bumstead and Orvan Hess saved a patient's life using Penicillin
Looking for a timeline maker?
Create timelines for projects, roadmaps, history, lessons, legal cases, and stories with Timetoast. Timetoast is a timeline maker for work, school, research, and stories.